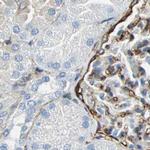
AKAP12 Antibody in Immunohistochemistry (IHC)

Search
Invitrogen
AKAP12 Polyclonal Antibody
{{$productOrderCtrl.translations['antibody.pdp.commerceCard.promotion.promotions']}}
{{$productOrderCtrl.translations['antibody.pdp.commerceCard.promotion.viewpromo']}}
{{$productOrderCtrl.translations['antibody.pdp.commerceCard.promotion.promocode']}}: {{promo.promoCode}} {{promo.promoTitle}} {{promo.promoDescription}}. {{$productOrderCtrl.translations['antibody.pdp.commerceCard.promotion.learnmore']}}
产品信息
PA5-52281
种属反应
宿主/亚型
分类
类型
抗原
偶联物
形式
浓度
规格
纯化类型
保存液
内含物
保存条件
运输条件
RRID
产品详细信息
Immunogen sequence: QRAEAERPEE QAEASGLKKE TDVVLKVDAQ EAKTEPFTQG KVVGQTTPES FEKAPQVTES IESSELVTTC QAETLAGVKS QEMVMEQAIP PDSVETPTDS ETDGST
Highest antigen sequence identity to the following orthologs: Mouse - 45%, Rat - 44%.
靶标信息
The A-kinase anchor proteins (AKAPs) are a group of structurally diverse proteins, which have the common function of binding to the regulatory subunit of protein kinase A (PKA) and confining the holoenzyme to discrete locations within the cell. This gene encodes a member of the AKAP family. The encoded protein is expressed in endothelial cells, cultured fibroblasts, and osteosarcoma cells. It associates with protein kinases A and C and phosphatase, and serves as a scaffold protein in signal transduction. This protein and RII PKA colocalize at the cell periphery. This protein is a cell growth-related protein. Antibodies to this protein can be produced by patients with myasthenia gravis. Alternative splicing of this gene results in two transcript variants encoding different isoforms.
仅用于科研。不用于诊断过程。未经明确授权不得转售。
篇参考文献 (0)
生物信息学
蛋白别名: A kinase (PRKA) anchor protein 12; A-kinase anchor protein 12; A-kinase anchor protein 250 kDa; A-kinase anchor protein, 250kDa; AKAP 250; AKAP-12; Gravin; kinase scaffold protein gravin; Myasthenia gravis autoantigen; myasthenia gravis autoantigen gravin; Src-Suppressed C Kinase Substrate
基因别名: AKAP12; AKAP250; SSeCKS
UniProt ID: (Human) Q02952
Entrez Gene ID: (Human) 9590